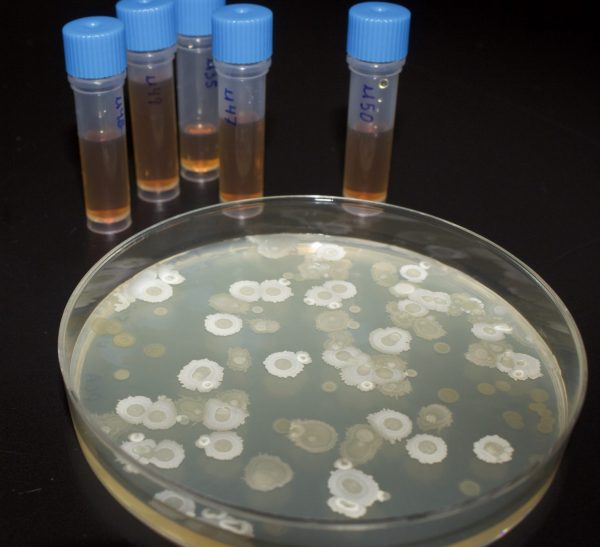

Optimisé vos cultures grâce à notre gamme Éra
Nos experts en fabrication de biostimulants travaillent à maximiser la production, la santé et le rendement de vos plantes et de vos cultures.


Boost Pro
Éra Boost Pro est un biostimulant microbien soigneusement formulé pour améliorer le rendement des plantes grâce à des rhizobactéries qui favorisent la croissance des plantes (PGPR).

Prevent
Éra Prevent est un biostimulant pour les plantes, spécialement développé pour améliorer leur vigueur.

N-Fix
Éra N-Fix est un produit microbien spécialement développé pour fixer l’azote atmosphérique et prodiguer à la plante un apport constant de cet élément essentiel.

L’importance des bactéries
Tout comme pour les humains, certaines souches de bactéries de type probiotique aident à la santé des plantes. Celle-ci est appelée bactérie rhizosphérique et elle favorise la croissance des plantes afin de les aider dans de nombreux processus métaboliques essentiels tels que l’acquisition de nutriment et la production de métabolique secondaire importante. Les pratiques agricoles modernes telles que la culture hors-sol ou hydroponique ont divisé cette symbiose naturelle. Développées par notre équipe de microbiologistes et d’agronomistes chevronnés, nos solutions de biostimulants à base de bactéries rhizosphériques élites permettent de recréer cette symbiose naturelle et ainsi améliorer la santé et la vigueur des plantes.
La force des molécules effectrices

Il est possible en utilisant certaines molécules clés de modifier le développement d’une plante. Les plantes possèdent un grand nombre de récepteurs afin de percevoir le monde qui les entoure, telles que la présence d’ennemies ou le manque d’eau. En manipulant ces récepteurs à l’aide de technologie issues de la chimie verte, il est possible d’optimiser le développement de la plante sans avoir recours à la chimie traditionnelle.